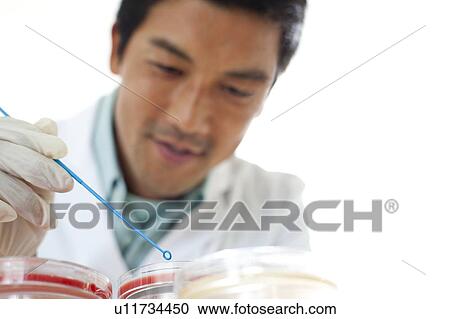

Fotosearch Royalty Free Stock Photography
Digital images licensed by Publitek, Inc.
Fotosearch and Photosearch are trademarks of Fotosearch, LLC
All rights reserved © 2025-10-25
Microbiology research Stock Image
Microbiology research
u11734450 | Lushpix | Royalty Free
Add to Lightbox
Share Image
Model Released
There is a signed model release for this image.
Keywords
30s, 35-359 years, adults only, biology, cell culture, close up, culture dish, front view, interior, laboratory, laboratory procedure, men only, microbe culture, microbiology, one person, petri dish, research, research process, scientist, small group of objects, swab, top section, women only, young adult, young men, young women, stock image, images, royalty free photo, stock photos, stock photograph, stock photographs, picture, pictures, graphic, graphics, fine art prints, print, poster, posters, mural, wall murals, u11734450
30s, 35-359 years, adults only, biology, cell culture, close up, culture dish, front view, interior, laboratory, laboratory procedure, men only, microbe culture, microbiology, one person, petri dish, research, research process, scientist, small group of objects, swab, top section, women only, young adult, young men, young women, stock image, images, royalty free photo, stock photos, stock photograph, stock photographs, picture, pictures, graphic, graphics, fine art prints, print, poster, posters, mural, wall murals, u11734450
Show Keywords
- Mobile/Small Web Resolution (150 KB)3.9" x 2.6" @ 72dpi JPG13
- Web Resolution (500 KB)7.1" x 4.8" @ 72dpi JPG32
- Low Resolution (1 MB)10.1" x 6.7" @ 72dpi JPG89
- Medium Resolution (10 MB)7.6" x 5.1" @ 300dpi JPG180
- High Resolution (28 MB)12.8" x 8.5" @ 300dpi JPG280
- Ultra High Resolution (60.2 MB)18.7" x 12.5" @ 300dpi JPG320
View larger image sizes
View Lushpix license agreement

























